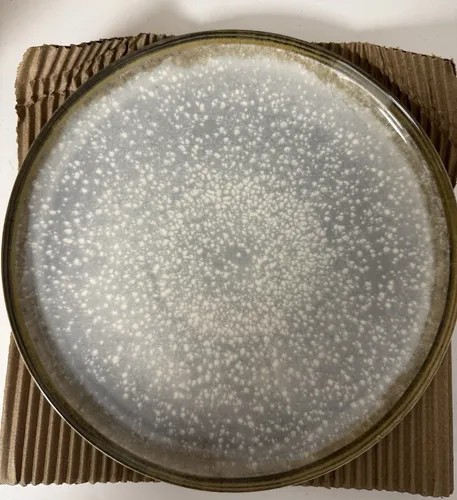
Moritz & Moritz BLOSSOM Geschirrset 18tlg - Komplett-Service aus hochwertigem Porzellan, spülmaschinenfest und mikrowellengeeignet. Perfekt für stilvolle Anlässe mit vintage floralem Design.

SÄNGER Kombiservice Bilgola Marmor 36-teiliges Geschirrset für 6 Personen - Kombiservice aus hochwertigem Porzellan mit elegantem Marmor Design. Perfekt für Dinnerpartys und den täglichen Gebrauch - 36 Teile für 6 Personen.
- Hersteller: Sänger
- Farbe: Marmor
Preisvergleich ab 99,99 € bis 119,99 €
-
Bestes Angebot

SÄNGER | Kombiservice Bilgola Marmor, 36-teiliges Geschirrset für 6 Personen mit Speise-, Dessert-, Suppentellern, Müslischalen, Kaffee- und Untertassen aus Porzellan, Eckig | PREMIUM COLLECTION
MARMOR DESIGN: Genießen Sie gemeinsam mit Ihren Liebsten jedes Dinner mit dem Geschirrset Bilgola Marmor Design. Ein 36-teiliges Set aus hochwertigem Porzellan für ein exquisites Geschmackserlebnis. Elegant gestaltet und ideal für den täglichen Gebrauch. GESCHIRRSET FÜR 6 PERSONEN: Mit unserem Bilgola Marmor Design Teller-Set in erhalten Sie 6 Speiseteller (⌀ 25cm), 6 Suppenteller (⌀ 21,5cm), 6 Müslischalen (⌀ 15cm), 6 Dessertteller (⌀ 18,5cm), 6 Kaffeetassen (⌀ 8cm) und 6 Untertassen (⌀ 14,4cm) im 36-teiligen Set – perfekt für ein 3-Gänge Menü mit den Liebsten. LEICHT ECKIGES DESIGN: Das Bilgola Tafelservice Marmor Design der Marke SÄNGER beeindruckt besonders durch seine abgerundeten Ecken. Jeder Teller wirkt modern und edel zugleich und ist universell einsetzbar. 𝐃𝐈𝐄 𝐌𝐀𝐑𝐊𝐄 𝐒Ä𝐍𝐆𝐄𝐑: Hier finden Sie eine große Auswahl an hochwertigem Geschirr. Wir setzen sowohl auf Optik als auch auf Qualität, von zeitlosen Designs bis zu außergewöhnlichen Unikaten. 𝐇𝐈𝐍𝐖𝐄𝐈𝐒: Aufgrund der Handfertigung kann jedes Set leicht variieren, was es noch individueller macht.

99,99 €
zzgl. 0,00 € VersandSÄNGER | Kombiservice Bilgola Marmor, 36-teiliges Geschirrset für 6 Personen mit Speise-, Dessert-, Suppentellern, Müslischalen, Kaffee- und Untertassen aus Porzellan, Eckig | PREMIUM COLLECTION
MARMOR DESIGN: Genießen Sie gemeinsam mit Ihren Liebsten jedes Dinner mit dem Geschirrset Bilgola Marmor Design. Ein 36-teiliges Set aus hochwertigem Porzellan für ein exquisites Geschmackserlebnis. Elegant gestaltet und ideal für den täglichen Gebrauch. GESCHIRRSET FÜR 6 PERSONEN: Mit unserem Bilgola Marmor Design Teller-Set in erhalten Sie 6 Speiseteller (⌀ 25cm), 6 Suppenteller (⌀ 21,5cm), 6 Müslischalen (⌀ 15cm), 6 Dessertteller (⌀ 18,5cm), 6 Kaffeetassen (⌀ 8cm) und 6 Untertassen (⌀ 14,4cm) im 36-teiligen Set – perfekt für ein 3-Gänge Menü mit den Liebsten. LEICHT ECKIGES DESIGN: Das Bilgola Tafelservice Marmor Design der Marke SÄNGER beeindruckt besonders durch seine abgerundeten Ecken. Jeder Teller wirkt modern und edel zugleich und ist universell einsetzbar. 𝐃𝐈𝐄 𝐌𝐀𝐑𝐊𝐄 𝐒Ä𝐍𝐆𝐄𝐑: Hier finden Sie eine große Auswahl an hochwertigem Geschirr. Wir setzen sowohl auf Optik als auch auf Qualität, von zeitlosen Designs bis zu außergewöhnlichen Unikaten. 𝐇𝐈𝐍𝐖𝐄𝐈𝐒: Aufgrund der Handfertigung kann jedes Set leicht variieren, was es noch individueller macht.
-

SÄNGER Tafelservice Bilgola Marmor (18-tlg), 6 Personen, Porzellan, Marmor, 24 tlg. Kombiservice, Erweiterbar, PREMIUM COLLECTION
TELLER SO SCHÖN WIE IM RESTAURANT Mit diesem Geschirrset von SÄNGER lässt sich wirklich jede Speise anrichten wie im fünf Sterne Restaurant. Das hochwertige Porzellan der Teller und Schalen und das einmalige Marmor Design machen dieses Set zum Must-Have für jedes gemeinsame Dinner. BESTSELLER QUALITÄT DIE ÜBERZEUGT Die Runde, leicht eckige Form ist universell einsetzbar und lenkt nicht vom Essen ab. Gleichzeitig strahlt das Marmor Design eine schöne Eleganz aus, die Ihr Dinner im neuen Glanze erstrahlen lässt. LIEFERUMFANG 6x Speiseteller - ØxH: 25 x 25 x 2,2 cm 6x Suppenteller - ØxH: 21,5 x 21,5 x 4 cm - Füllmenge 500 ml 6x Dessertteller - ØxH: 18,5 x 18,5 x 2 cm 6x Müslischalen - ØxH: 15 x 4,5 cm - Füllmenge 300 ml 6x Tassen - ØxH: 8 x 6,6 cm – Füllmenge 175 ml 6x Untertassen - LxBxH: 14,4 x 14,4 x 1,6 cm Qualität fängt bei der Herstellung an Hier finden Sie eine große Auswahl an hochwertigem Geschirr. Wir setzen sowohl auf Optik als auch auf Qualität, von zeitlosen Designs bis zu außergewöhnlichen Unikaten. Hinweis Aufgrund der Handfertigung kann jedes Set leicht variieren, was es noch individueller macht. Dekorationsartikel gehören nicht zum Leistungsumfang. Bitte entnehmen Sie alle dazugehörigen Teile dem Feld "Lieferumfang".

104,99 €
zzgl. 4,08 € VersandSÄNGER Tafelservice Bilgola Marmor (18-tlg), 6 Personen, Porzellan, Marmor, 24 tlg. Kombiservice, Erweiterbar, PREMIUM COLLECTION
TELLER SO SCHÖN WIE IM RESTAURANT Mit diesem Geschirrset von SÄNGER lässt sich wirklich jede Speise anrichten wie im fünf Sterne Restaurant. Das hochwertige Porzellan der Teller und Schalen und das einmalige Marmor Design machen dieses Set zum Must-Have für jedes gemeinsame Dinner. BESTSELLER QUALITÄT DIE ÜBERZEUGT Die Runde, leicht eckige Form ist universell einsetzbar und lenkt nicht vom Essen ab. Gleichzeitig strahlt das Marmor Design eine schöne Eleganz aus, die Ihr Dinner im neuen Glanze erstrahlen lässt. LIEFERUMFANG 6x Speiseteller - ØxH: 25 x 25 x 2,2 cm 6x Suppenteller - ØxH: 21,5 x 21,5 x 4 cm - Füllmenge 500 ml 6x Dessertteller - ØxH: 18,5 x 18,5 x 2 cm 6x Müslischalen - ØxH: 15 x 4,5 cm - Füllmenge 300 ml 6x Tassen - ØxH: 8 x 6,6 cm – Füllmenge 175 ml 6x Untertassen - LxBxH: 14,4 x 14,4 x 1,6 cm Qualität fängt bei der Herstellung an Hier finden Sie eine große Auswahl an hochwertigem Geschirr. Wir setzen sowohl auf Optik als auch auf Qualität, von zeitlosen Designs bis zu außergewöhnlichen Unikaten. Hinweis Aufgrund der Handfertigung kann jedes Set leicht variieren, was es noch individueller macht. Dekorationsartikel gehören nicht zum Leistungsumfang. Bitte entnehmen Sie alle dazugehörigen Teile dem Feld "Lieferumfang".
-

Sänger Kombiservice, Weiß, Keramik, 36-teilig, 25x6.6x15 cm, kratzfest, Essen & Trinken, Geschirr, Geschirr-Sets, Kombiservice
Teller SO Schön WIE IM Restaurant Mit diesem Geschirrset von Sänger lässt sich wirklich jede Speise anrichten wie im fünf Sterne Restaurant. Das hochwertige Porzellan der Teller und Schalen und das einmalige Marmor Design machen dieses Set zum Must-Have für jedes gemeinsame Dinner. Bestseller Qualität DIE Überzeugt Die Runde, leicht eckige Form ist universell einsetzbar und lenkt nicht vom Essen ab. Gleichzeitig strahlt das Marmor Design eine schöne Eleganz aus, die Ihr Dinner im neuen Glanze erstrahlen lässt. Lieferumfang 6x Speiseteller - ØxH: 25 x 25 x 2,2 cm 6x Suppenteller - ØxH: 21,5 x 21,5 x 4 cm - Füllmenge 500 ml 6x Dessertteller - ØxH: 18,5 x 18,5 x 2 cm 6x Müslischalen - ØxH: 15 x 4,5 cm - Füllmenge 300 ml 6x Tassen - ØxH: 8 x 6,6 cm – Füllmenge 175 ml 6x Untertassen - LxBxH: 14,4 x 14,4 x 1,6 cm Qualität fängt bei der Herstellung an Hier finden Sie eine große Auswahl an hochwertigem Geschirr. Wir setzen sowohl auf Optik als auch auf Qualität, von zeitlosen Designs bis zu außergewöhnlichen Unikaten. Hinweis Aufgrund der Handfertigung kann jedes Set leicht variieren, was es noch individueller macht. Dekorationsartikel gehören nicht zum Leistungsumfang. Bitte entnehmen Sie alle dazugehörigen Teile dem Feld 'Lieferumfang'.

109,99 €
zzgl. 0,00 € VersandSänger Kombiservice, Weiß, Keramik, 36-teilig, 25x6.6x15 cm, kratzfest, Essen & Trinken, Geschirr, Geschirr-Sets, Kombiservice
Teller SO Schön WIE IM Restaurant Mit diesem Geschirrset von Sänger lässt sich wirklich jede Speise anrichten wie im fünf Sterne Restaurant. Das hochwertige Porzellan der Teller und Schalen und das einmalige Marmor Design machen dieses Set zum Must-Have für jedes gemeinsame Dinner. Bestseller Qualität DIE Überzeugt Die Runde, leicht eckige Form ist universell einsetzbar und lenkt nicht vom Essen ab. Gleichzeitig strahlt das Marmor Design eine schöne Eleganz aus, die Ihr Dinner im neuen Glanze erstrahlen lässt. Lieferumfang 6x Speiseteller - ØxH: 25 x 25 x 2,2 cm 6x Suppenteller - ØxH: 21,5 x 21,5 x 4 cm - Füllmenge 500 ml 6x Dessertteller - ØxH: 18,5 x 18,5 x 2 cm 6x Müslischalen - ØxH: 15 x 4,5 cm - Füllmenge 300 ml 6x Tassen - ØxH: 8 x 6,6 cm – Füllmenge 175 ml 6x Untertassen - LxBxH: 14,4 x 14,4 x 1,6 cm Qualität fängt bei der Herstellung an Hier finden Sie eine große Auswahl an hochwertigem Geschirr. Wir setzen sowohl auf Optik als auch auf Qualität, von zeitlosen Designs bis zu außergewöhnlichen Unikaten. Hinweis Aufgrund der Handfertigung kann jedes Set leicht variieren, was es noch individueller macht. Dekorationsartikel gehören nicht zum Leistungsumfang. Bitte entnehmen Sie alle dazugehörigen Teile dem Feld 'Lieferumfang'.
-

SÄNGER Tafelservice Bilgola Marmor, Weiß (36-tlg), 6 Personen, Porzellan, Kombiservice, Erweiterbar, PREMIUM COLLECTION
TELLER SO SCHÖN WIE IM RESTAURANT Mit diesem Geschirrset von SÄNGER lässt sich wirklich jede Speise anrichten wie im fünf Sterne Restaurant. Das hochwertige Porzellan der Teller und Schalen und das einmalige Marmor Design machen dieses Set zum Must-Have für jedes gemeinsame Dinner. BESTSELLER QUALITÄT DIE ÜBERZEUGT Die Runde, leicht eckige Form ist universell einsetzbar und lenkt nicht vom Essen ab. Gleichzeitig strahlt das Marmor Design eine schöne Eleganz aus, die Ihr Dinner im neuen Glanze erstrahlen lässt. LIEFERUMFANG 6x Speiseteller - ØxH: 25 x 25 x 2,2 cm 6x Suppenteller - ØxH: 21,5 x 21,5 x 4 cm - Füllmenge 500 ml 6x Dessertteller - ØxH: 18,5 x 18,5 x 2 cm 6x Müslischalen - ØxH: 15 x 4,5 cm - Füllmenge 300 ml 6x Tassen - ØxH: 8 x 6,6 cm – Füllmenge 175 ml 6x Untertassen - LxBxH: 14,4 x 14,4 x 1,6 cm Qualität fängt bei der Herstellung an Hier finden Sie eine große Auswahl an hochwertigem Geschirr. Wir setzen sowohl auf Optik als auch auf Qualität, von zeitlosen Designs bis zu außergewöhnlichen Unikaten. Hinweis Aufgrund der Handfertigung kann jedes Set leicht variieren, was es noch individueller macht. Dekorationsartikel gehören nicht zum Leistungsumfang. Bitte entnehmen Sie alle dazugehörigen Teile dem Feld "Lieferumfang".

109,99 €
zzgl. 4,08 € VersandSÄNGER Tafelservice Bilgola Marmor, Weiß (36-tlg), 6 Personen, Porzellan, Kombiservice, Erweiterbar, PREMIUM COLLECTION
TELLER SO SCHÖN WIE IM RESTAURANT Mit diesem Geschirrset von SÄNGER lässt sich wirklich jede Speise anrichten wie im fünf Sterne Restaurant. Das hochwertige Porzellan der Teller und Schalen und das einmalige Marmor Design machen dieses Set zum Must-Have für jedes gemeinsame Dinner. BESTSELLER QUALITÄT DIE ÜBERZEUGT Die Runde, leicht eckige Form ist universell einsetzbar und lenkt nicht vom Essen ab. Gleichzeitig strahlt das Marmor Design eine schöne Eleganz aus, die Ihr Dinner im neuen Glanze erstrahlen lässt. LIEFERUMFANG 6x Speiseteller - ØxH: 25 x 25 x 2,2 cm 6x Suppenteller - ØxH: 21,5 x 21,5 x 4 cm - Füllmenge 500 ml 6x Dessertteller - ØxH: 18,5 x 18,5 x 2 cm 6x Müslischalen - ØxH: 15 x 4,5 cm - Füllmenge 300 ml 6x Tassen - ØxH: 8 x 6,6 cm – Füllmenge 175 ml 6x Untertassen - LxBxH: 14,4 x 14,4 x 1,6 cm Qualität fängt bei der Herstellung an Hier finden Sie eine große Auswahl an hochwertigem Geschirr. Wir setzen sowohl auf Optik als auch auf Qualität, von zeitlosen Designs bis zu außergewöhnlichen Unikaten. Hinweis Aufgrund der Handfertigung kann jedes Set leicht variieren, was es noch individueller macht. Dekorationsartikel gehören nicht zum Leistungsumfang. Bitte entnehmen Sie alle dazugehörigen Teile dem Feld "Lieferumfang".
-

SÄNGER Porzellan Kombiservice Bilgola Marmor 36 teilig für 6 Personen
TELLER SO SCHÖN WIE IM RESTAURANTMit diesem Geschirrset von SÄNGER lässt sich wirklich jede Speise anrichten wie im fünf Sterne Restaurant. Das hochwertige Porzellan der Teller und Schalen und das einmalige Marmor Design machen dieses Set zum Must-Have für jedes gemeinsame Dinner. QUALITÄT DIE ÜBERZEUGTDie Runde, leicht eckige Form ist universell einsetzbar und lenkt nicht vom Essen ab. Gleichzeitig strahlt das Marmor Design eine schöne Eleganz aus, die Ihr Dinner im neuen Glanze erstrahlen lässt.LIEFERUMFANG6x Speiseteller - ØxH: 25 x 25 x 2,2 cm6x Suppenteller - ØxH: 21,5 x 21,5 x 4 cm - Füllmenge 500 ml6x Dessertteller - ØxH: 18,5 x 18,5 x 2 cm6x Müslischalen - ØxH: 15 x 4,5 cm - Füllmenge 300 ml6x Tassen - ØxH: 8 x 6,6 cm – Füllmenge 175 ml6x Untertassen - LxBxH: 14,4 x 14,4 x 1,6 cmQualität fängt bei der Herstellung anHier finden Sie eine große Auswahl an hochwertigem Geschirr. Wir setzen sowohl auf Optik als auch auf Qualität, von zeitlosen Designs bis zu außergewöhnlichen Unikaten.HinweisAufgrund der Handfertigung kann jedes Set leicht variieren, was es noch individueller macht.Dekorationsartikel gehören nicht zum Leistungsumfang. Bitte entnehmen Sie alle dazugehörigen Teile dem Feld "Lieferumfang".

119,99 €
zzgl. 0,00 € VersandSÄNGER Porzellan Kombiservice Bilgola Marmor 36 teilig für 6 Personen
TELLER SO SCHÖN WIE IM RESTAURANTMit diesem Geschirrset von SÄNGER lässt sich wirklich jede Speise anrichten wie im fünf Sterne Restaurant. Das hochwertige Porzellan der Teller und Schalen und das einmalige Marmor Design machen dieses Set zum Must-Have für jedes gemeinsame Dinner. QUALITÄT DIE ÜBERZEUGTDie Runde, leicht eckige Form ist universell einsetzbar und lenkt nicht vom Essen ab. Gleichzeitig strahlt das Marmor Design eine schöne Eleganz aus, die Ihr Dinner im neuen Glanze erstrahlen lässt.LIEFERUMFANG6x Speiseteller - ØxH: 25 x 25 x 2,2 cm6x Suppenteller - ØxH: 21,5 x 21,5 x 4 cm - Füllmenge 500 ml6x Dessertteller - ØxH: 18,5 x 18,5 x 2 cm6x Müslischalen - ØxH: 15 x 4,5 cm - Füllmenge 300 ml6x Tassen - ØxH: 8 x 6,6 cm – Füllmenge 175 ml6x Untertassen - LxBxH: 14,4 x 14,4 x 1,6 cmQualität fängt bei der Herstellung anHier finden Sie eine große Auswahl an hochwertigem Geschirr. Wir setzen sowohl auf Optik als auch auf Qualität, von zeitlosen Designs bis zu außergewöhnlichen Unikaten.HinweisAufgrund der Handfertigung kann jedes Set leicht variieren, was es noch individueller macht.Dekorationsartikel gehören nicht zum Leistungsumfang. Bitte entnehmen Sie alle dazugehörigen Teile dem Feld "Lieferumfang".
Gut zu wissen
Ähnliche Produkte

Tafelservice porzellan, LOVECASA SWEET 16-teiliges Kombiservice bunt, Ess Geschirrset für 4 Personen | Speiseteller, Tassen, Dessertteller und Schüsseln, VCP-GDS8, Hellblau
79,99 €
Amazon.de

Moritz & Moritz Kombiservice ORGANIC Geschirrset mit Tassen 24tlg Blau (24-tlg), 6 Personen, Steinzeug, Kombigeschirr für 6 Personen
149,99 €
Amazon.de

Moritz & Moritz Kombiservice ORGANIC Geschirrset mit Tassen 24tlg Beige (24-tlg), 6 Personen, Steinzeug, Kombigeschirr für 6 Personen
149,99 €
Amazon.de

Moritz & Moritz SOLID 18-tlg Geschirr Set für 6 Personen - Elegantes Steinzeug Geschirrset mit 6x Speisetellern, Desserttellern und Suppentellern. Ideal für besondere Anlässe oder den täglichen Gebrauch, backofen- und spülmaschinengeeignet.
119,99 €
Amazon.de

Steingut Geschirrset 6 Pers. Rustic 24-tlg - Hochwertiges Tafelservice - Tafelservice für 6 Personen im modernen Vintage-Look, pflegeleicht und spülmaschinenfest. Ideal für Alltag und besondere Anlässe!
119,95 €
Amazon.de
Moritz & Moritz BLOSSOM Geschirrset 18tlg - Komplett-Service aus hochwertigem Porzellan, spülmaschinenfest und mikrowellengeeignet. Perfekt für stilvolle Anlässe mit vintage floralem Design.
99,99 €
Amazon.de

CreaTable 17407 Serie Folklore 16-teiliges Geschirrset - Kombiservice aus robustem Steinzeug, spülmaschinen- und mikrowellengeeignet mit fröhlichem, skandinavischem Blumendesign für jeden Anlass.
67,99 €
Amazon.de

Moritz & Moritz Tafelservice ORGANIC reaktiv amber 18-tlg. Geschirrset - Elegantes Steinzeug-Geschirrset für 6 Personen, unifarbenes Design in Beige, ideal für stilvolle Tischdekoration.
119,99 €
Amazon.de

Moritz & Moritz Tafelservice ORGANIC reaktiv grau 18-tlg. für 6 Personen - Hochwertiges Steinzeug-Geschirrset in schlichtem grauen Design, ideal für stilvolle Tischdekorationen und den täglichen Gebrauch.
119,99 €
Amazon.de

Moritz & Tafelservice 18-tlg. Blau Reaktiv - Stilvoller Tischgenuss - Services: 18-teiliges Tafelservice aus hochwertigem Steinzeug in blau und mattschwarz. Mikrowellengeeignet und ideal für stilvolle Anlässe. Perfekt für ein ansprechendes Gedeck!
99,99 €
Amazon.de
